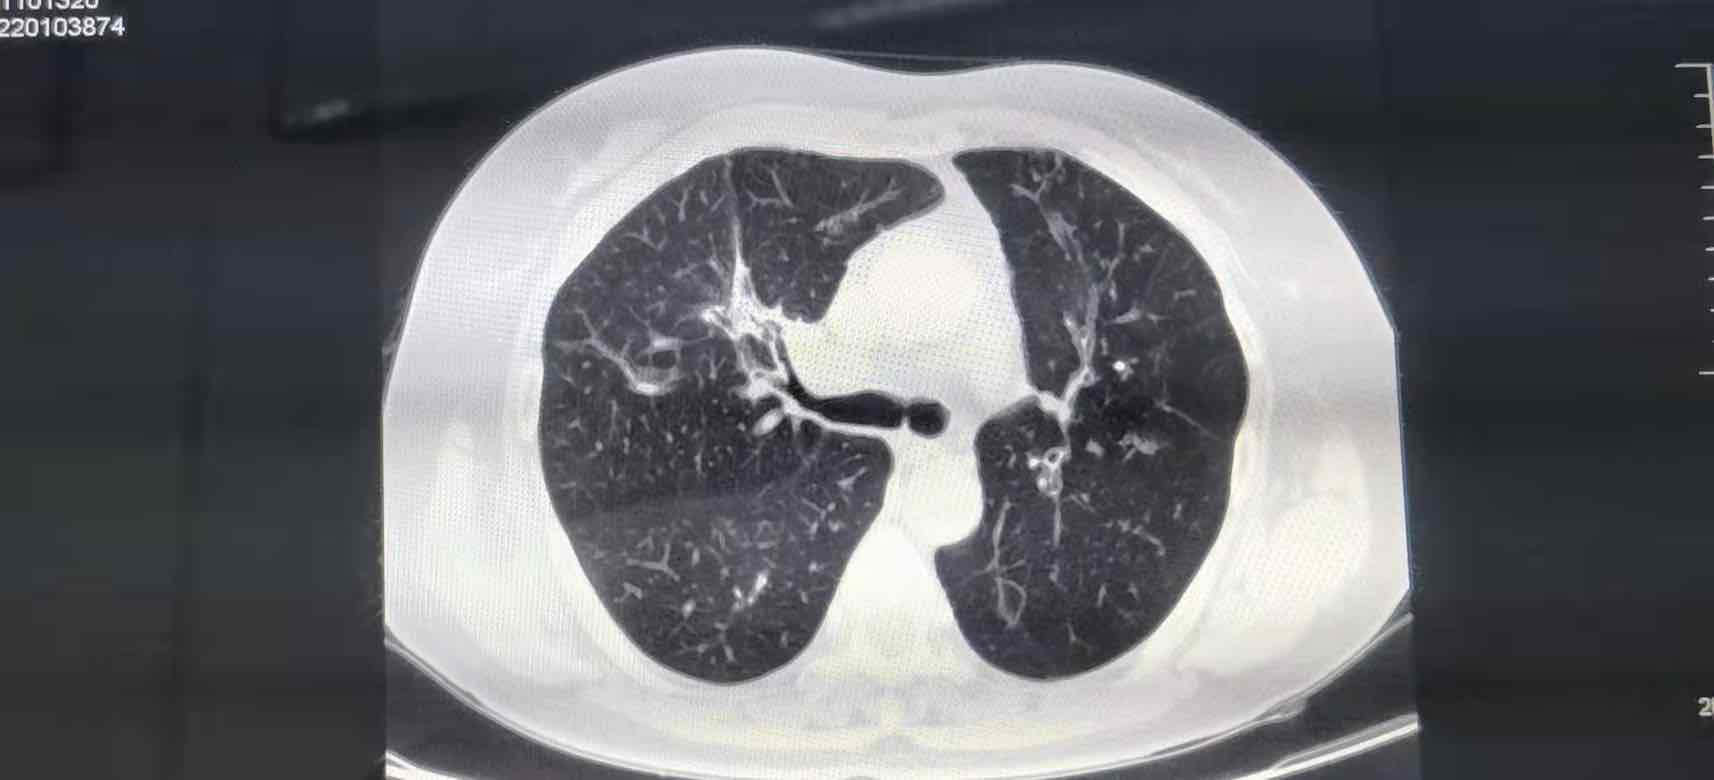

参与评论
评论列表
按投票顺序
加油
举报
2022-04-16 19:06:34 有用(0)
回复(0)
效果很好
举报
2022-04-16 20:18:48 有用(0)
回复(0)
英勇的松鼠3436卧槽好牛
举报
2022-04-23 08:34:03 有用(0)
回复(0)
大胆的针织衫您好 您母亲的基因检测是哪个突变呢 MET14突变可以吃这个药吗
举报
2022-04-16 21:14:50 有用(0)
回复(3)
震动的铁链克唑我们吃了三个月了,脸肿,脚肿,手肿。
举报
2022-04-17 19:53:40 有用(0)
回复(0)
震动的铁链Ros1突变
举报
2022-04-17 19:53:55 有用(0)
回复(0)
大力的水桶83831.11日病灶2.8✖️3.5
举报
2022-04-18 18:40:15 有用(0)
回复(0)
我也是吃的克唑替尼,己经18个月了。目前病情稳定。我是EML4(ALK阳性)
举报
2022-04-18 06:48:31 有用(0)
回复(0)
不错,继续加油,吃到cr
举报
2022-04-17 07:59:48 有用(0)
回复(1)
相关推荐
热点推荐
2013-11-19 14:23:04
爸爸确诊病情已经有11个多月了。一共做了8次大化疗,2次小化疗,以及35次放疗,上月返医院检查“瘤子”没有了。这一路走来,有多少的艰辛与泪水。在这里与大家分享爸爸的治疗过程。起初,拿到病例报告的时候,
2013-11-19 14:31:01
妈妈患肺癌已经有三年了,这三年来一直在接受治疗到现在,下面是妈妈检查以及治疗的过程。2010年10月,妈妈体检出肺癌IV期,纵隔淋巴转移,肝部转移,去省肿瘤医院复查,做了PET-CT,结果一样,省肿瘤
2013-11-19 15:04:43
2011年11月,妈妈被诊断肺癌,我在网上浏览了很多帖子,学到了很多,看到了一批又一批共同奋斗在抗癌战线上的战友。这15个月走下来,越来越体会到抗癌之路的艰辛,今天发个帖子,记录一下妈妈的治疗经过,也